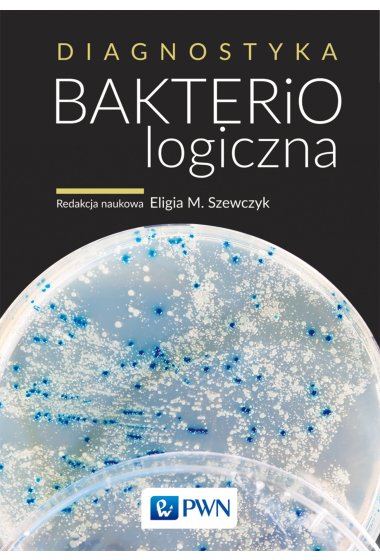

| Wydawnictwo: | Wydawnictwo Naukowe PWN |
| Kod: | TO4069 |
| ISBN: | 9788301205508 |
| Numer wydania: | Wydanie 3 |
| Data premiery: | 20.06.2019 |
| Format: | 165 mm x 235 mm |
| Oprawa: | miękka |
| Ilość stron: | 620 |
Diagnostyka bakteriologiczna
Diagnostyka bakteriologiczna
NOWE, ZMIENIONE, POSZERZONE, TRZECIE WYDANIE TEJ KSIĄŻKI
JEDYNY NA POLSKIM RYNKU PODRĘCZNIK DIAGNOSTYKI ZAKAŻEŃ BAKTERYJNYCH
DIAGNOSTYKA MIKROBIOLOGICZNA PRZEDSTAWIONA W KONTEKŚCIE NAJNOWSZYCH BADAŃ MIKROBIOMU CZŁOWIEKA
W książce między innymi:
- Opis najważniejszych i mniej znanych bakterii związanych z człowiekiem uwzględniający ich aktualną pozycję taksonomiczną, nazewnictwo, znaczenie kliniczne i czynniki ich chorobotwórczości, cechy morfologiczne i hodowlane, różnicowanie względem bakterii pokrewnych lub podobnych.
- Bakterie tworzące mikrobiom człowieka – znaczenie dla diagnostyki chorób.
- Hodowlane i niehodowlane metody diagnostyczne oparte o najnowsze rekomendacje krajowych i europejskich towarzystw naukowych i zespołów lekarzy i diagnostów Narodowego Programu Ochrony Antybiotyków
- Informacje o sposobach pobierania materiałów klinicznych i ich transportu.
- Omówienie diagnostyki zakażeń w obrębie wszystkich narządów i układów. Hodowla, różnicowanie w oparciu o właściwości metaboliczne, cechy biologiczne, serologicznie, a także metody wysokoprzepływowe i molekularne.
- Szerokie informacje o zakażeniach przenoszonych przez wektory owadzie.
- Wskazówki dotyczące badań wirusologicznych i parazytologicznych.
- Zakażenia szpitalne, zagrożenia ze strony szczepów wieloopornych i dochodzenia epidemiologiczne
- Obszerny aneks z opisem wszystkich istotnych w diagnostyce i wskazanych w książce podłoży i metod diagnostycznych.
Autorami tego trzeciego wydania książki jest zespół pracowników naukowych Zakładu Mikrobiologii Farmaceutycznej i Diagnostyki Mikrobiologicznej Uniwersytetu Medycznego w Łodzi, a także takie czołowe postaci polskiej mikrobiologii jak Ewa Augustynowicz-Kopeć, Waleria Hryniewicz i Alina Olender.
Publikacja jest kierowana do studentów i osób specjalizujących się w zawodach medycznych, zwłaszcza diagnostów laboratoryjnych a także studentów wydziałów lekarskich, nauk o zdrowiu i farmacji oraz do szerokiego grona studentów mikrobiologii, biotechnologii czy ochrony środowiska.
Jest pozycją z pewnością bardzo przydatną w medycznych laboratoriach diagnostycznych i stacjach sanitarno-epidemiologicznych.
WYDAWNICTWO NAUKOWE PWN SPÓŁKA AKCYJNA
UL. GOTTLIEBA DAIMLERA 2
02-460 Warszawa
Polska
Kontakt
E-mail: dyrektywa@pwn.pl
| DPD Pickup punkt odbioru/ automat paczkowy | od 9.99 zł |
| InPost Paczkomat 24/7 | od 13 zł |
| Punkt DHL Parcelshop | od 14 zł |
| Firma kurierska | od 14 zł |
| Firma kurierska DHL | od 14 zł |
| Kurier DPD | od 14 zł |
| Kurier Inpost | od 14 zł |
| Darmowa dostawa | od 159 zł |
Brak ocen.
Bądź pierwszy i dodaj opinię.